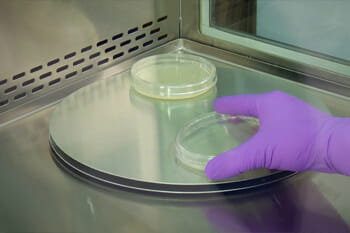
Biosafety Cabinet Ergonomics

Biosafety Cabinet Ergonomics
Ergonomics is crucial in creating a safe and comfortable laboratory environment. The video “Biosafety Cabinet Ergonomics” demonstrates how NuAire Biological Safety Cabinets (BSCs) are designed to support proper posture, reduce strain, and enhance overall efficiency in the lab.
When you work in a NuAire BSC, you’ll experience a workspace that is ergonomically designed to work with you, not against you. NuAire BSCs provide maximum knee and thigh clearance, allowing users to assume proper posture. This feature is essential for maintaining comfort during long hours of laboratory work.
NuAire offers a variety of base stands, from fixed and telescoping to automatically adjustable, providing customization to meet individual needs. The new air armrests add additional forearm support for procedures performed within the cabinet, helping to reduce strain.
Standard armrests are manufactured from PVC plastics to minimize cold conduction, which can affect tendon constriction. For additional comfort, optional disposable foam pads are available. The spacious, effective work zone area in NuAire BSCs helps reduce arm, neck, and shoulder strain by bringing the proper work area closer to the user and minimizing fatigue.
Ergonomic accessories further enhance the ergonomic work zone. A stainless steel turntable extends the reach of users by up to twelve inches into the back corners of the work zone. At the same time, closed-cell foam padded elbow rests provide variety for repetitious activities such as pipetting and keeping the airfoil unlocked. Additionally, a footrest under the cabinet supports correct body positions, and an ergonomically designed chair helps correct improper body posture.
NuAire’s cool lighting reduces glare, making it easier to focus on work and reducing eye fatigue. The frameless polished edge window allows for greater visibility and better sight lines to the effective work area, reducing awkward posture and minimizing eye and neck strain.
A range of accessory options is available to make your BSC workspace even more ergonomically friendly. These features collectively ensure that laboratory personnel can work comfortably and efficiently, reducing the risk of repetitive strain injuries and enhancing overall productivity.


















